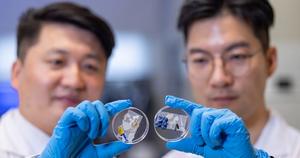

PolyU Research Reveals Hidden Microbial Dangers from Plastic Waste, Calls for Global Efforts to Monitor Harmful Microbiomes
PolyU Research Reveals Hidden Microbial Dangers from Plastic Waste, Calls for Global Efforts to Monitor Harmful Microbiomes
In a groundbreaking study emanating from the Hong Kong Polytechnic University (PolyU), researchers have revealed the intricate and largely concealed microbial ecosystems thriving on plastic waste, exposing unprecedented threats to natural environments worldwide. This revelation underscores the urgency for a robust global collaboration aimed at comprehensively tracking and mitigating the impact of these harmful microbiomes, which could have far-reaching consequences on ecological health and human safety.
Plastic pollution, a pervasive and escalating environmental crisis, has become a substrate for the formation of complex microbial communities. Contrary to the traditional view of plastics as inert pollutants, this new research elucidates how plastic debris serves as a vector for microbial colonization, fostering unique biofilms known as the “plastisphere.” These microbial assemblages harbor diverse populations, including pathogenic bacteria, antibiotic-resistant genes, and toxin-producing species, all of which can disseminate through aquatic and terrestrial ecosystems.
The PolyU team employed advanced metagenomic sequencing and high-resolution imaging technologies to characterize microbial diversity and function on various types of plastic debris collected from marine and freshwater environments. Their findings indicate that plastic surfaces not only facilitate biofilm formation but also promote horizontal gene transfer among microbes, potentially accelerating the evolution of virulence and resistance traits within these assemblages.
One of the most alarming aspects of this research is the identification of several opportunistic pathogens that could pose direct threats to wildlife and human populations. These pathogens demonstrate enhanced survival and dispersal mechanisms when associated with plastic carriers, effectively turning plastic pollution into a conduit for disease propagation across ecological boundaries. This phenomenon highlights a critical but previously underappreciated pathway for the spread of infectious agents enabled by anthropogenic waste.
Moreover, the microbial communities on plastics exhibit distinct metabolic pathways that enable degradation of certain polymer types, though at rates insufficient to alleviate pollution levels in meaningful timeframes. Such biodegradation potential, while scientifically intriguing, also raises concerns regarding the byproducts generated during plastic breakdown, many of which may be toxic or bioactive, thereby exacerbating environmental contamination.
The study also stresses the challenges in monitoring and controlling these microbial populations due to their dynamic nature and vast genetic diversity. Traditional microbiological methods fall short of capturing the complexity of plastisphere communities, necessitating the integration of multi-omic approaches, including metatranscriptomics and metabolomics, to unravel functional attributes and ecological impacts thoroughly.
In response to these findings, the authors advocate for an international framework that unites environmental microbiologists, ecologists, policymakers, and public health experts to systematically investigate and mitigate the risks associated with plastic-associated microbiomes. This collaborative network would enable data sharing, standardization of monitoring protocols, and development of innovative intervention strategies to curb the proliferation of harmful microbes.
An intriguing but little-explored aspect of this research pertains to the influence of environmental variables such as temperature, pH, salinity, and nutrient availability on the composition and behavior of microbial consortia on plastics. Understanding these parameters could inform predictive models that forecast microbial community shifts under different pollution scenarios, essential for proactive environmental management.
Furthermore, the study brings to light potential feedback loops where microbial activity on plastics impacts broader biogeochemical cycles, including carbon and nitrogen transformations. The interaction of plastisphere microbes with native microbial communities could alter nutrient dynamics, with implications for ecosystem productivity and resilience.
Despite its profound implications, the research acknowledges several gaps, particularly in understanding the long-term ecological consequences of plastisphere proliferation and the pathways through which these microbes transfer to terrestrial habitats and human populations. Addressing these gaps requires sustained investment in longitudinal studies and environmental surveillance programs.
In technological terms, the research leverages the synergy between next-generation sequencing platforms and machine learning algorithms to dissect complex data sets, providing unprecedented resolution into microbial taxonomy and functionality. This approach represents a paradigm shift in environmental microbiology, enabling real-time assessment of pollution-driven microbial hazards.
The implications of this research extend beyond environmental science, touching upon public health, biotechnology, and waste management sectors. By elucidating the microbial dimension of plastic pollution, the study calls for holistic policies that integrate microbial threat assessments into environmental regulations and plastic production standards.
Ultimately, this pivotal research from PolyU crystallizes a new frontier in the understanding of plastic pollution, elevating microbial ecology to a central role in addressing one of the 21st century’s most stubborn environmental challenges. The message is clear: tackling plastic waste is not merely about removing physical debris but also about confronting the invisible and insidious microbial menaces it carries.
Subject of Research: Microbial communities associated with plastic pollution and their ecological and health impacts
Article Title: PolyU research unveils hidden microbial threats to ecosystem caused by plastic waste, urging global collaboration to track harmful microbiomes
Image Credits: Hong Kong Polytechnic University (PolyU) / EurekAlert!
Pediatric Investigation Uncovers Immune Mechanisms Behind Medulloblastoma Metastasis Through Explainable AI
Next PostSn-Enhanced Catalyst Significantly Improves Diesel Emission Control Performance
Team-Based Insights Transform Self-Blood Pressure Monitoring Outcomes

